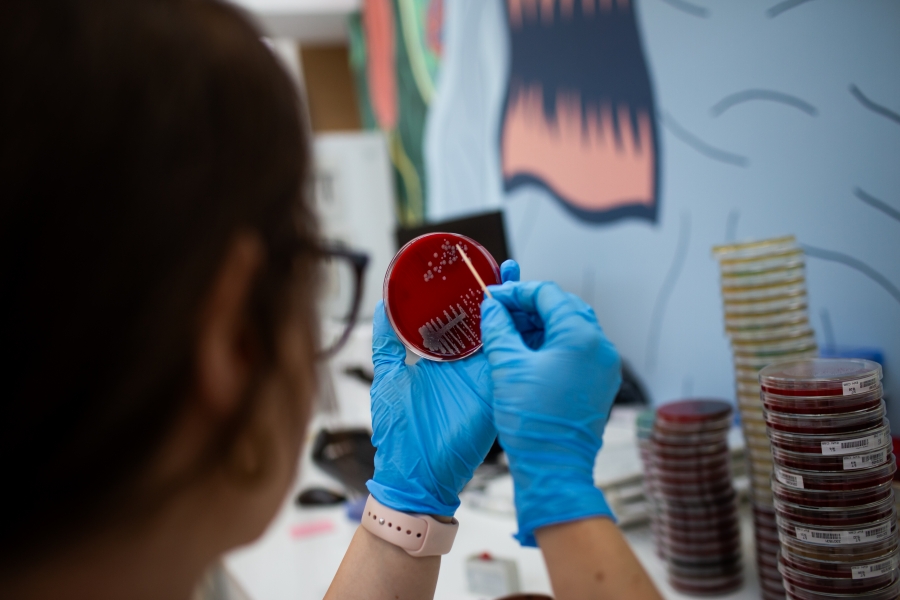

Imaginați-vă un milion și jumătate de euro într-o cameră frigorifică de pe Splaiul Independenței, din București. Nu, nu e un enunț din acela menit să vă facă să dați click. E realitate.
Citeste integral - click aici
Articolul "În culisele unui laborator medical high tech din România. Călătorie în locul unde viitorul se întâmplă azi" a fost redactat de Diana Marcu si a fost preluat din publicatia online Republica.ro